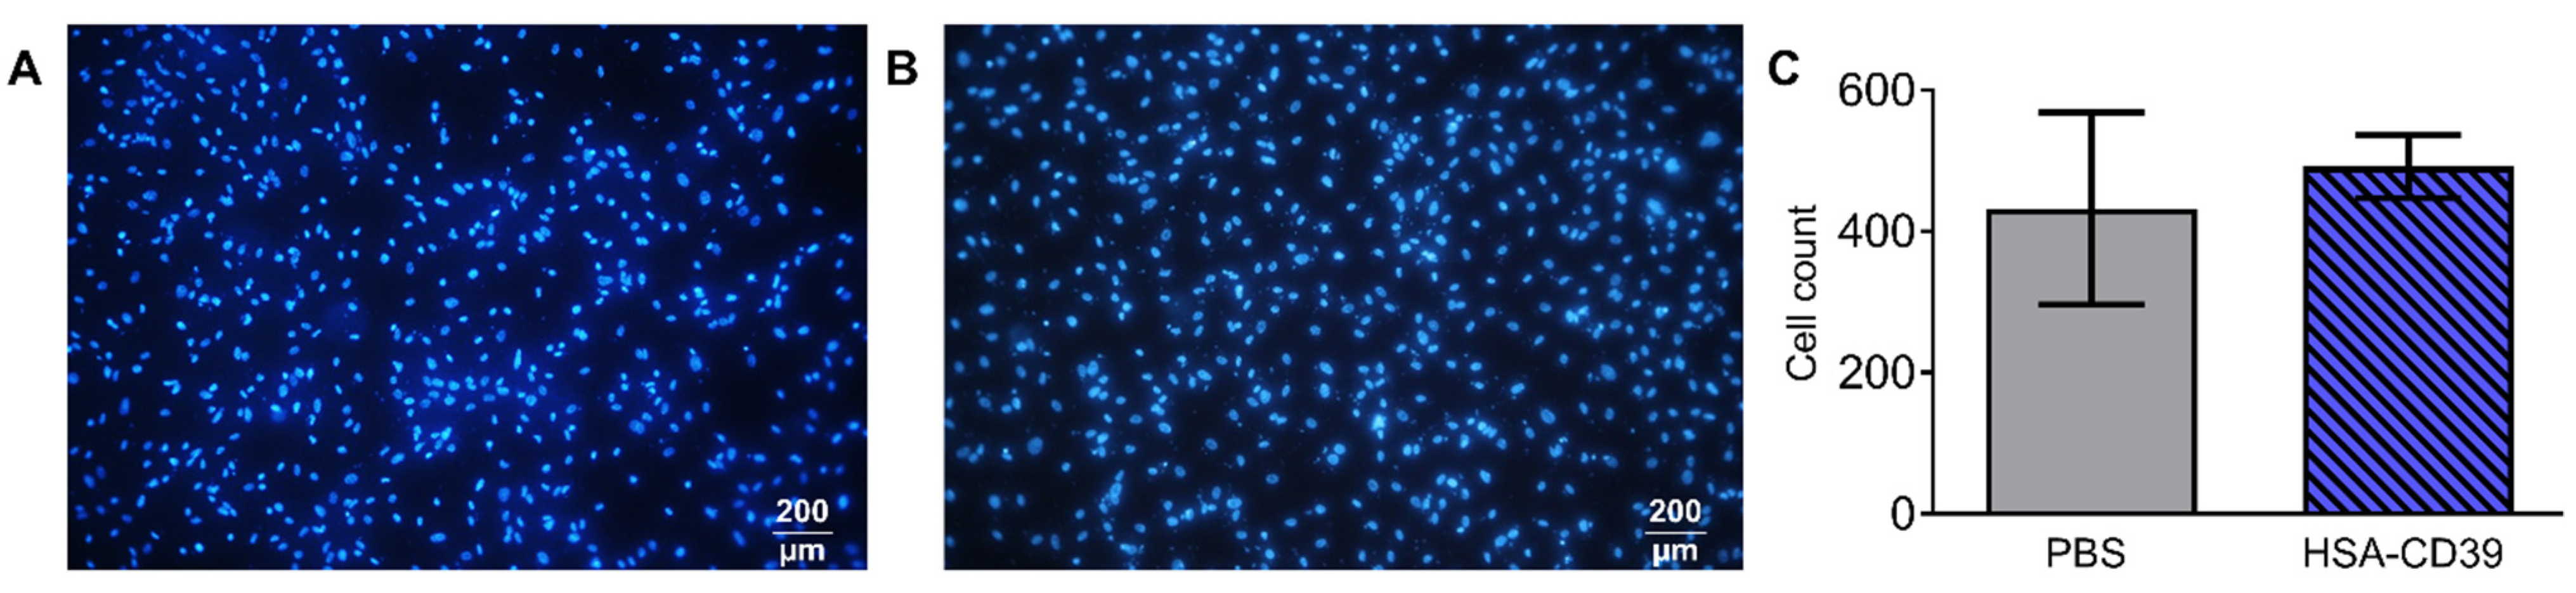

A Recombinant Fusion Construct between Human Serum Albumin and NTPDase CD39 Allows Anti-Inflammatory and Anti-Thrombotic Coating of Medical Devices
Abstract
1. Introduction
2. Materials and Methods
2.1. Generation of Recombinant Fusion Construct, Production, Expression of Protein and Purification
2.2. Blood Sampling from Healthy Human Volunteers
2.3. Preparation of Platelet-Rich Plasma
2.4. Flow Cytometry
2.5. ADP Bioluminescence Assay
2.6. Lyophilisation of Protein
2.7. Coating of Stent Material for In Vitro Analysis
2.8. Endothelialisation Analysis of Protein-Coated Nitinol BlueOxide Plates
2.9. In Vitro Haemocompatibility Testing Using Roller Pump and Modified Chandler Loop Model
2.10. Statistical Analysis
3. Results
3.1. Generation, Production and Enzymatic Activity of Recombinant Fusion Protein HSA-CD39
3.2. In Vitro Analysis of Environmental Stability of HSA-CD39 Fusion Protein and Coating
3.3. HSA-CD39 Fusion Protein as an Anti-Thrombotic Coating for Different Medical Materials
3.4. HSA-CD39 Fusion Protein Coating Allows for Endothelialisation
3.5. Haemocompatibility and In Vitro Proof of Function of HSA-CD39-Coated Nitinol Blue Oxide Stents and PVC Tubes
4. Discussion
5. Conclusions
Supplementary Materials
Author Contributions
Funding
Institutional Review Board Statement
Informed Consent Statement
Data Availability Statement
Acknowledgments
Conflicts of Interest
References
- WHO. The Top 10 Causes of Death. Available online: http://www.who.int/mediacentre/factsheets/fs310/en/ (accessed on 21 August 2020).
- Biran, R.; Pond, D. Heparin coatings for improving blood compatibility of medical devices. Adv. Drug Deliv. Rev. 2017, 112, 12–23. [Google Scholar] [CrossRef]
- Jaffer, I.H.; Fredenburgh, J.C.; Hirsh, J.; Weitz, J.I. Medical device-induced thrombosis: What causes it and how can we prevent it? J. Thromb. Haemost. JTH 2015, 13 (Suppl. S1), S72–S81. [Google Scholar] [CrossRef]
- Hickman, D.A.; Pawlowski, C.L.; Sekhon, U.D.S.; Marks, J.; Gupta, A.S. Biomaterials and Advanced Technologies for Hemostatic Management of Bleeding. Adv. Mater. 2018, 30, 1700859. [Google Scholar] [CrossRef]
- Asada, Y.; Yamashita, A.; Sato, Y.; Hatakeyama, K. Thrombus Formation and Propagation in the Onset of Cardiovascular Events. J. Atheroscler. Thromb. 2018, 25, 653–664. [Google Scholar] [CrossRef]
- Dutra, G.V.S.; Neto, W.S.; Dutra, J.P.S.; Machado, F. Implantable Medical Devices and Tissue Engineering: An Overview of Manufacturing Processes and the Use of Polymeric Matrices for Manufacturing and Coating their Surfaces. Curr. Med. Chem. 2020, 27, 1580–1599. [Google Scholar] [CrossRef] [PubMed]
- Lavery, K.S.; Rhodes, C.; Mcgraw, A.; Eppihimer, M.J. Anti-thrombotic technologies for medical devices. Adv. Drug Deliv. Rev. 2017, 112, 2–11. [Google Scholar] [CrossRef] [PubMed]
- Thomas, J.; Kostousov, V.; Teruya, J. Bleeding and Thrombotic Complications in the Use of Extracorporeal Membrane Oxygenation. Semin. Thromb. Hemost. 2018, 44, 20–29. [Google Scholar] [CrossRef]
- Sun, W.; Wang, S.; Chen, Z.; Zhang, J.; Li, T.; Arias, K.; Griffith, B.P.; Wu, Z.J. Impact of high mechanical shear stress and oxygenator membrane surface on blood damage relevant to thrombosis and bleeding in a pediatric ECMO circuit. Artif. Organs 2020, 44, 717–726. [Google Scholar] [CrossRef]
- Wendel, H.P.; Hauser, N.; Briquet, F.; Ziemer, G. Hemocompatibility of medical connectors with biopassive or bioactive surface coatings. J. Biomater. Appl. 2002, 17, 5–17. [Google Scholar] [CrossRef] [PubMed]
- Bertrand, O.F.; Sipehia, R.; Mongrain, R.; Rodés, J.; Tardif, J.C.; Bilodeau, L.; Côté, G.; Bourassa, M.G. Biocompatibility aspects of new stent technology. J. Am. Coll. Cardiol. 1998, 32, 562–571. [Google Scholar] [CrossRef]
- Hoffman, J.I.E.; Kaplan, S. The incidence of congenital heart disease. J. Am. Coll. Cardiol. 2002, 39, 1890–1900. [Google Scholar] [CrossRef]
- Lukovic, D.; Nyolczas, N.; Hemetsberger, R.; Pavo, I.J.; Pósa, A.; Behnisch, B.; Horak, G.; Zlabinger, K.; Gyöngyösi, M. Human recombinant activated protein C-coated stent for the prevention of restenosis in porcine coronary arteries. J. Mater. Sci. Mater. Med. 2015, 26, 241. [Google Scholar] [CrossRef][Green Version]
- Buccheri, D.; Piraino, D.; Andolina, G.; Cortese, B. Understanding and managing in-stent restenosis: A review of clinical data, from pathogenesis to treatment. J. Thorac. Dis. 2016, 8, E1150–E1162. [Google Scholar] [CrossRef]
- Khan, S.U.; Singh, M.; Valavoor, S.; Khan, M.U.; Lone, A.N.; Khan, M.Z.; Khan, M.S.; Mani, P.; Kapadia, S.R.; Michos, E.D.; et al. Dual Antiplatelet Therapy After Percutaneous Coronary Intervention and Drug-Eluting Stents: A Systematic Review and Network Meta-Analysis. Circulation 2020, 142, 1425–1436. [Google Scholar] [CrossRef]
- Nicolais, C.; Lakhter, V.; Virk, H.U.H.; Sardar, P.; Bavishi, C.; O’Murchu, B.; Chatterjee, S. Therapeutic Options for In-Stent Restenosis. Curr. Cardiol. Rep. 2018, 20, 7. [Google Scholar] [CrossRef]
- Li, Q.; Hegner, F.; Bruecker, C.H. Comparative Study of Wall-Shear Stress at the Ascending Aorta for Different Mechanical Heart Valve Prostheses. J. Biomech. Eng. 2020, 142, 011006. [Google Scholar] [CrossRef]
- Labarrere, C.A.; Dabiri, A.E.; Kassab, G.S. Thrombogenic and Inflammatory Reactions to Biomaterials in Medical Devices. Front. Bioeng. Biotechnol. 2020, 8, 123. [Google Scholar] [CrossRef] [PubMed]
- McGinty, S. A decade of modelling drug release from arterial stents. Math. Biosci. 2014, 257, 80–90. [Google Scholar] [CrossRef] [PubMed]
- Rykowska, I.; Nowak, I.; Nowak, R. Drug-Eluting Stents and Balloons-Materials, Structure Designs, and Coating Techniques: A Review. Molecules 2020, 25, 4624. [Google Scholar] [CrossRef] [PubMed]
- Lekshmi, K.M.; Che, H.-L.; Cho, C.-S.; Park, I.-K. Drug- and Gene-eluting Stents for Preventing Coronary Restenosis. Chonnam Med. J. 2017, 53, 14–27. [Google Scholar] [CrossRef] [PubMed]
- Busch, R.; Strohbach, A.; Rethfeldt, S.; Walz, S.; Busch, M.; Petersen, S.; Felix, S.; Sternberg, K. New stent surface materials: The impact of polymer-dependent interactions of human endothelial cells, smooth muscle cells, and platelets. Acta Biomater. 2014, 10, 688–700. [Google Scholar] [CrossRef] [PubMed]
- Torii, S.; Jinnouchi, H.; Sakamoto, A.; Mori, H.; Park, J.; Amoa, F.C.; Sawan, M.; Sato, Y.; Cornelissen, A.; Kuntz, S.H.; et al. Vascular responses to coronary calcification following implantation of newer-generation drug-eluting stents in humans: Impact on healing. Eur. Heart J. 2020, 41, 786–796. [Google Scholar] [CrossRef] [PubMed]
- Essandoh, M.; Dalia, A.A.; Albaghdadi, M.; George, B.; Stoicea, N.; Shabsigh, M.; Rao, S.V. Perioperative Management of Dual-Antiplatelet Therapy in Patients With New-Generation Drug-Eluting Metallic Stents and Bioresorbable Vascular Scaffolds Undergoing Elective Noncardiac Surgery. J. Cardiothorac. Vasc. Anesth. 2017, 31, 1857–1864. [Google Scholar] [CrossRef] [PubMed]
- Shlofmitz, E.; Iantorno, M.; Waksman, R. Restenosis of Drug-Eluting Stents: A New Classification System Based on Disease Mechanism to Guide Treatment and State-of-the-Art Review. Circ. Cardiovasc. Interv. 2019, 12, e007023. [Google Scholar] [CrossRef]
- Freitas, S.C.; Maia, S.; Figueiredo, A.C.; Gomes, P.; Pereira, P.J.B.; Barbosa, M.A.; Martins, M.C.L. Selective albumin-binding surfaces modified with a thrombin-inhibiting peptide. Acta Biomater. 2014, 10, 1227–1237. [Google Scholar] [CrossRef][Green Version]
- Zoellner, H.; Höfler, M.; Beckmann, R.; Hufnagl, P.; Vanyek, E.; Bielek, E.; Wojta, J.; Fabry, A.; Lockie, S.; Binder, B.R. Serum albumin is a specific inhibitor of apoptosis in human endothelial cells. J. Cell Sci. 1996, 109, 2571–2580. [Google Scholar] [CrossRef]
- Krajewski, S.; Neumann, B.; Kurz, J.; Perle, N.; Avci-Adali, M.; Cattaneo, G.; Wendel, H.P. Preclinical Evaluation of the Thrombogenicity and Endothelialization of Bare Metal and Surface-Coated Neurovascular Stents. Am. J. Neuroradiol. 2015, 36, 133–139. [Google Scholar] [CrossRef]
- Celik, I.E.; Yarlioglues, M.; Kurtul, A.; Duran, M.; Koseoglu, C.; Oksuz, F.; Aksoy, O.; Murat, S.N. Preprocedural Albumin Levels and Risk of In-Stent Restenosis After Coronary Stenting With Bare-Metal Stent. Angiology 2016, 67, 478–483. [Google Scholar] [CrossRef]
- Mulvihill, J.N.; Faradji, A.; Oberling, F.; Cazenave, J.P. Surface passivation by human albumin of plasmapheresis circuits reduces platelet accumulation and thrombus formation. Experimental and clinical studies. J. Biomed. Mater. Res. 1990, 24, 155–163. [Google Scholar] [CrossRef] [PubMed]
- Hyun, H.; Park, J.; Willis, K.; Park, J.E.; Lyle, L.T.; Lee, W.; Yeo, Y. Surface modification of polymer nanoparticles with native albumin for enhancing drug delivery to solid tumors. Biomaterials 2018, 180, 206–224. [Google Scholar] [CrossRef] [PubMed]
- Klinger, A.; Steinberg, D.; Kohavi, D.; Sela, M.N. Mechanism of adsorption of human albumin to titanium in vitro. J. Biomed. Mater. Res. 1997, 36, 387–392. [Google Scholar] [CrossRef]
- D’Elia, N.L.; Gravina, N.; Ruso, J.M.; Marco-Brown, J.L.; Sieben, J.M.; Messina, P.V. Albumin-mediated deposition of bone-like apatite onto nano-sized surfaces: Effect of surface reactivity and interfacial hydration. J. Colloid Interface Sci. 2017, 494, 345–354. [Google Scholar] [CrossRef]
- Tao, C.; Zhu, W.; Iqbal, J.; Xu, C.; Wang, D.-A. Stabilized albumin coatings on engineered xenografts for attenuation of acute immune and inflammatory responses. J. Mater. Chem. B 2020, 8, 6080–6091. [Google Scholar] [CrossRef] [PubMed]
- Oriňaková, R.; Gorejová, R.; Králová, Z.O.; Oriňak, A.; Shepa, I.; Hovancová, J.; Kovalčíková, A.; Bujňáková, Z.L.; Király, N.; Kaňuchová, M.; et al. Influence of albumin interaction on corrosion resistance of sintered iron biomaterials with polyethyleneimine coating. Appl. Surf. Sci. 2020, 509, 145379. [Google Scholar] [CrossRef]
- Kaczmarek, E.; Koziak, K.; Sévigny, J.; Siegel, J.B.; Anrather, J.; Beaudoin, A.R.; Bach, F.H.; Robson, S.C. Identification and characterization of CD39/vascular ATP diphosphohydrolase. J. Biol. Chem. 1996, 271, 33116–33122. [Google Scholar] [CrossRef]
- Fung, C.Y.E.; Marcus, A.J.; Broekman, M.J.; Mahaut-Smith, M.P. P2x1 receptor inhibition and soluble CD39 administration as novel approaches to widen the cardiovascular therapeutic window. Trends Cardiovasc. Med. 2009, 19, 1–5. [Google Scholar] [CrossRef] [PubMed][Green Version]
- Granja, T.; Körner, A.; Glück, C.; Hohmann, J.D.; Wang, X.; Köhler, D.; Streißenberger, A.; Nandurkar, H.H.; Mirakaj, V.; Rosenberger, P.; et al. Targeting CD39 Toward Activated Platelets Reduces Systemic Inflammation and Improves Survival in Sepsis: A Preclinical Pilot Study. Crit. Care Med. 2019, 47, e420–e427. [Google Scholar] [CrossRef]
- Hohmann, J.D.; Wang, X.; Krajewski, S.; Selan, C.; Haller, C.A.; Straub, A.; Chaikof, E.L.; Nandurkar, H.H.; Hagemeyer, C.E.; Peter, K. Delayed targeting of CD39 to activated platelet GPIIb/IIIa via a single-chain antibody: Breaking the link between antithrombotic potency and bleeding? Blood 2013, 121, 3067–3075. [Google Scholar] [CrossRef]
- Ziegler, M.; Hohmann, J.D.; Searle, A.K.; Abraham, M.-K.; Nandurkar, H.H.; Wang, X.; Peter, K. A single-chain antibody-CD39 fusion protein targeting activated platelets protects from cardiac ischaemia/reperfusion injury. Eur. Heart J. 2018, 39, 111–116. [Google Scholar] [CrossRef] [PubMed]
- Straub, A.; Krajewski, S.; Hohmann, J.D.; Westein, E.; Jia, F.; Bassler, N.; Selan, C.; Kurz, J.; Wendel, H.P.; Dezfouli, S.; et al. Evidence of platelet activation at medically used hypothermia and mechanistic data indicating ADP as a key mediator and therapeutic target. Arterioscler. Thromb. Vasc. Biol. 2011, 31, 1607–1616. [Google Scholar] [CrossRef]
- Abraham, M.-K.; Nolte, A.; Reus, R.; Behring, A.; Zengerle, D.; Avci-Adali, M.; Hohmann, J.D.; Peter, K.; Schlensak, C.; Wendel, H.P.; et al. In vitro Study of a Novel Stent Coating Using Modified CD39 Messenger RNA to Potentially Reduce Stent Angioplasty-Associated Complications. PLoS ONE 2015, 10, e0138375. [Google Scholar] [CrossRef] [PubMed]
- Abraham, M.-K.; Peter, K.; Michel, T.; Wendel, H.P.; Krajewski, S.; Wang, X. Nanoliposomes for Safe and Efficient Therapeutic mRNA Delivery: A Step Toward Nanotheranostics in Inflammatory and Cardiovascular Diseases as well as Cancer. Nanotheranostics 2017, 1, 154–165. [Google Scholar] [CrossRef] [PubMed][Green Version]
- Covarrubias, R.; Chepurko, E.; Reynolds, A.; Huttinger, Z.M.; Huttinger, R.; Stanfill, K.; Wheeler, D.G.; Novitskaya, T.; Robson, S.C.; Dwyer, K.M.; et al. Role of the CD39/CD73 Purinergic Pathway in Modulating Arterial Thrombosis in Mice. Arterioscler. Thromb. Vasc. Biol. 2016, 36, 1809–1820. [Google Scholar] [CrossRef] [PubMed]
- Allard, B.; Longhi, M.S.; Robson, S.C.; Stagg, J. The ectonucleotidases CD39 and CD73: Novel checkpoint inhibitor targets. Immunol. Rev. 2017, 276, 121–144. [Google Scholar] [CrossRef]
- Robson, S.C.; Wu, Y.; Sun, X.; Knosalla, C.; Dwyer, K.; Enjyoji, K. Ectonucleotidases of CD39 family modulate vascular inflammation and thrombosis in transplantation. Semin. Thromb. Hemost. 2005, 31, 217–233. [Google Scholar] [CrossRef] [PubMed]
- Avci-Adali, M.; Kobba, J.; Neumann, B.; Lescan, M.; Perle, N.; Wilhelm, N.; Wiedmaier, H.; Schlensak, C.; Wendel, H.P. Application of a rotating bioreactor consisting of low-cost and ready-to-use medical disposables for in vitro evaluation of the endothelialization efficiency of small-caliber vascular prostheses: Rotating Bioreactor for Investigation of Endothelialization. J. Biomed. Mater. Res. B Appl. Biomater. 2013, 101B, 1061–1068. [Google Scholar] [CrossRef] [PubMed]
- Krajewski, S.; Prucek, R.; Panacek, A.; Avci-Adali, M.; Nolte, A.; Straub, A.; Zboril, R.; Wendel, H.P.; Kvitek, L. Hemocompatibility evaluation of different silver nanoparticle concentrations employing a modified Chandler-loop in vitro assay on human blood. Acta Biomater. 2013, 9, 7460–7468. [Google Scholar] [CrossRef]
- Wendel, H.P.; Ziemer, G. Coating-techniques to improve the hemocompatibility of artificial devices used for extracorporeal circulation. Eur. J. Cardio-Thorac. Surg. 1999, 16, 342–350. [Google Scholar] [CrossRef]
- Farhatnia, Y.; Tan, A.; Motiwala, A.; Cousins, B.G.; Seifalian, A.M. Evolution of covered stents in the contemporary era: Clinical application, materials and manufacturing strategies using nanotechnology. Biotechnol. Adv. 2013, 31, 524–542. [Google Scholar] [CrossRef]
- Joung, Y.-H. Development of implantable medical devices: From an engineering perspective. Int. Neurourol. J. 2013, 17, 98–106. [Google Scholar] [CrossRef]
- Marcus, A.J.; Broekman, M.J.; Drosopoulos, J.H.; Islam, N.; Alyonycheva, T.N.; Safier, L.B.; Hajjar, K.A.; Posnett, D.N.; Schoenborn, M.A.; Schooley, K.A.; et al. The endothelial cell ecto-ADPase responsible for inhibition of platelet function is CD39. J. Clin. Investig. 1997, 99, 1351–1360. [Google Scholar] [CrossRef]
- Marcus, A.J.; Broekman, M.J.; Drosopoulos, J.H.; Pinsky, D.J.; Islam, N.; Maliszewsk, C.R. Inhibition of platelet recruitment by endothelial cell CD39/ecto-ADPase: Significance for occlusive vascular diseases. Ital. Heart J. 2001, 2, 824–830. [Google Scholar] [PubMed]
- Cai, M.; Huttinger, Z.M.; He, H.; Zhang, W.; Li, F.; Goodman, L.A.; Wheeler, D.G.; Druhan, L.J.; Zweier, J.L.; Dwyer, K.M.; et al. Transgenic over expression of ectonucleotide triphosphate diphosphohydrolase-1 protects against murine myocardial ischemic injury. J. Mol. Cell. Cardiol. 2011, 51, 927–935. [Google Scholar] [CrossRef]
- Marcus, A.J.; Broekman, M.J.; Drosopoulos, J.H.F.; Olson, K.E.; Islam, N.; Pinsky, D.J.; Levi, R. Role of CD39 (NTPDase-1) in thromboregulation, cerebroprotection, and cardioprotection. Semin. Thromb. Hemost. 2005, 31, 234–246. [Google Scholar] [CrossRef]
- Huttinger, Z.M.; Milks, M.W.; Nickoli, M.S.; Aurand, W.L.; Long, L.C.; Wheeler, D.G.; Dwyer, K.M.; d’Apice, A.J.F.; Robson, S.C.; Cowan, P.J.; et al. Ectonucleotide Triphosphate Diphosphohydrolase-1 (CD39) Mediates Resistance to Occlusive Arterial Thrombus Formation after Vascular Injury in Mice. Am. J. Pathol. 2012, 181, 322–333. [Google Scholar] [CrossRef] [PubMed]
- Wang, X.; Peter, K. Molecular Imaging of Atherothrombotic Diseases: Seeing Is Believing. Arterioscler. Thromb. Vasc. Biol. 2017, 37, 1029–1040. [Google Scholar] [CrossRef] [PubMed]
- Wang, X.; Hagemeyer, C.E.; Hohmann, J.D.; Leitner, E.; Armstrong, P.C.; Jia, F.; Olschewski, M.; Needles, A.; Peter, K.; Ahrens, I. Novel Single-Chain Antibody-Targeted Microbubbles for Molecular Ultrasound Imaging of Thrombosis: Validation of a Unique Noninvasive Method for Rapid and Sensitive Detection of Thrombi and Monitoring of Success or Failure of Thrombolysis in Mice. Circulation 2012, 125, 3117–3126. [Google Scholar] [CrossRef]
- Hanjaya-Putra, D.; Haller, C.; Wang, X.; Dai, E.; Lim, B.; Liu, L.; Jaminet, P.; Yao, J.; Searle, A.; Bonnard, T.; et al. Platelet-targeted dual pathway antithrombotic inhibits thrombosis with preserved hemostasis. JCI Insight 2018, 3, e99329. [Google Scholar] [CrossRef]
- Wang, X.; Gkanatsas, Y.; Palasubramaniam, J.; Hohmann, J.D.; Chen, Y.C.; Lim, B.; Hagemeyer, C.; Peter, K. Thrombus-Targeted Theranostic Microbubbles: A New Technology towards Concurrent Rapid Ultrasound Diagnosis and Bleeding-free Fibrinolytic Treatment of Thrombosis. Theranostics 2016, 6, 726–738. [Google Scholar] [CrossRef]
- Tao, C.; Chuah, Y.J.; Xu, C.; Wang, D.-A. Albumin conjugates and assemblies as versatile bio-functional additives and carriers for biomedical applications. J. Mater. Chem. B 2019, 7, 357–367. [Google Scholar] [CrossRef]
- Merlot, A.M.; Kalinowski, D.S.; Richardson, D.R. Unraveling the mysteries of serum albumin-more than just a serum protein. Front. Physiol. 2014, 5, 299. [Google Scholar] [CrossRef]
- Kratz, F. Albumin as a drug carrier: Design of prodrugs, drug conjugates and nanoparticles. J. Control. Release 2008, 132, 171–183. [Google Scholar] [CrossRef] [PubMed]
- Höhn, S.; Braem, A.; Neirinck, B.; Virtanen, S. Albumin coatings by alternating current electrophoretic deposition for improving corrosion resistance and bioactivity of titanium implants. Mater. Sci. Eng. C 2017, 73, 798–807. [Google Scholar] [CrossRef] [PubMed]
- Goodman, S.L.; Cooper, S.L.; Albrecht, R.M. The effects of substrate-adsorbed albumin on platelet spreading. J. Biomater. Sci. Polym. Ed. 1991, 2, 147–159. [Google Scholar] [CrossRef]
- Mason, R.G.; Shermer, R.W.; Zucker, W.H. Effects of certain purified plasma proteins on the compatibility of glass with blood. Am. J. Pathol. 1973, 73, 183–200. [Google Scholar]
- Kottke-Marchant, K.; Anderson, J.M.; Umemura, Y.; Marchant, R.E. Effect of albumin coating on the in vitro blood compatibility of Dacron® arterial prostheses. Biomaterials 1989, 10, 147–155. [Google Scholar] [CrossRef]
- Guidoin, R.; Snyder, R.; Martin, L.; Botzko, K.; Marois, M.; Awad, J.; King, M.; Domurado, D.; Bedros, M.; Gosselin, C. Albumin coating of a knitted polyester arterial prosthesis: An alternative to preclotting. Ann. Thorac. Surg. 1984, 37, 457–465. [Google Scholar] [CrossRef]
- Ji, J.; Tan, Q.; Fan, D.-Z.; Sun, F.-Y.; Barbosa, M.A.; Shen, J. Fabrication of alternating polycation and albumin multilayer coating onto stainless steel by electrostatic layer-by-layer adsorption. Colloids Surf. B Biointerfaces 2004, 34, 185–190. [Google Scholar] [CrossRef] [PubMed]
- Kinnari, T.J.; Peltonen, L.I.; Kuusela, P.; Kivilahti, J.; Könönen, M.; Jero, J. Bacterial adherence to titanium surface coated with human serum albumin. Otol. Neurotol. 2005, 26, 380–384. [Google Scholar] [CrossRef]
- Van De Keere, I.; Willaert, R.; Tourwé, E.; Hubin, A.; Vereecken, J. The interaction of human serum albumin with titanium studied by means of atomic force microscopy. Surf. Interface Anal. 2008, 40, 157–161. [Google Scholar] [CrossRef]
- Lambert, B.J.; Mendelson, T.A.; Craven, M.D. Radiation and Ethylene Oxide Terminal Sterilization Experiences with Drug Eluting Stent Products. AAPS PharmSciTech 2011, 12, 1116–1126. [Google Scholar] [CrossRef]
- Shintani, H. Ethylene Oxide Gas Sterilization of Medical Devices. Biocontrol Sci. 2017, 22, 1–16. [Google Scholar] [CrossRef]
- Barras, C.D.; Myers, K.A. Nitinol—its use in vascular surgery and other applications. Eur. J. Vasc. Endovasc. Surg. 2000, 19, 564–569. [Google Scholar] [CrossRef] [PubMed]
- Nathan, A.; Kobayashi, T.; Giri, J. Nitinol Self-Expanding Stents for the Superficial Femoral Artery. Interv. Cardiol. Clin. 2017, 6, 227–233. [Google Scholar] [CrossRef] [PubMed]
- Akgul, E.; Onan, H.B.; Akpinar, S.; Balli, H.T.; Aksungur, E.H. The DERIVO Embolization Device in the Treatment of Intracranial Aneurysms: Short- and Midterm Results. World Neurosurg. 2016, 95, 229–240. [Google Scholar] [CrossRef] [PubMed]
- Wu, X.; Yin, T.; Tian, J.; Tang, C.; Huang, J.; Zhao, Y.; Zhang, X.; Deng, X.; Fan, Y.; Yu, D.; et al. Distinctive effects of CD34- and CD133-specific antibody-coated stents on re-endothelialization and in-stent restenosis at the early phase of vascular injury. Regen. Biomater. 2015, 2, 87–96. [Google Scholar] [CrossRef]
- Aoki, J.; Serruys, P.W.; van Beusekom, H.; Ong, A.T.L.; McFadden, E.P.; Sianos, G.; van der Giessen, W.J.; Regar, E.; de Feyter, P.J.; Davis, H.R.; et al. Endothelial Progenitor Cell Capture by Stents Coated With Antibody Against CD34: The HEALING-FIM (Healthy Endothelial Accelerated Lining Inhibits Neointimal Growth-First In Man) Registry. J. Am. Coll. Cardiol. 2005, 45, 1574–1579. [Google Scholar] [CrossRef] [PubMed]

Publisher’s Note: MDPI stays neutral with regard to jurisdictional claims in published maps and institutional affiliations. |
© 2021 by the authors. Licensee MDPI, Basel, Switzerland. This article is an open access article distributed under the terms and conditions of the Creative Commons Attribution (CC BY) license (https://creativecommons.org/licenses/by/4.0/).
Share and Cite
Abraham, M.-K.; Jost, E.; Hohmann, J.D.; Searle, A.K.; Bongcaron, V.; Song, Y.; Wendel, H.P.; Peter, K.; Krajewski, S.; Wang, X. A Recombinant Fusion Construct between Human Serum Albumin and NTPDase CD39 Allows Anti-Inflammatory and Anti-Thrombotic Coating of Medical Devices. Pharmaceutics 2021, 13, 1504. https://doi.org/10.3390/pharmaceutics13091504
Abraham M-K, Jost E, Hohmann JD, Searle AK, Bongcaron V, Song Y, Wendel HP, Peter K, Krajewski S, Wang X. A Recombinant Fusion Construct between Human Serum Albumin and NTPDase CD39 Allows Anti-Inflammatory and Anti-Thrombotic Coating of Medical Devices. Pharmaceutics. 2021; 13(9):1504. https://doi.org/10.3390/pharmaceutics13091504
Chicago/Turabian StyleAbraham, Meike-Kristin, Elena Jost, Jan David Hohmann, Amy Kate Searle, Viktoria Bongcaron, Yuyang Song, Hans Peter Wendel, Karlheinz Peter, Stefanie Krajewski, and Xiaowei Wang. 2021. "A Recombinant Fusion Construct between Human Serum Albumin and NTPDase CD39 Allows Anti-Inflammatory and Anti-Thrombotic Coating of Medical Devices" Pharmaceutics 13, no. 9: 1504. https://doi.org/10.3390/pharmaceutics13091504
APA StyleAbraham, M.-K., Jost, E., Hohmann, J. D., Searle, A. K., Bongcaron, V., Song, Y., Wendel, H. P., Peter, K., Krajewski, S., & Wang, X. (2021). A Recombinant Fusion Construct between Human Serum Albumin and NTPDase CD39 Allows Anti-Inflammatory and Anti-Thrombotic Coating of Medical Devices. Pharmaceutics, 13(9), 1504. https://doi.org/10.3390/pharmaceutics13091504

